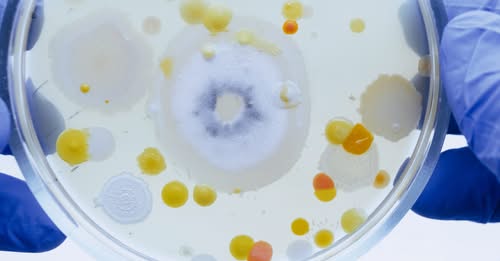

A miniszterelnök szerint bebizonyosodott, hogy a Tisza Párt képviselői a magyarok ellen dolgoznak…

Komment - Ítélethirdetés az egyik legrejtélyesebb magyar bűnügyben. 27 év után született jogerős ítélet a magyar kriminalisztika egyik legszövevényesebb ügyében. Fenyő János médiavállalkozó 1998-as meggyilkolásáért Gyárfás Tamás felbujtóként 7 évet kapott, a per másik vádlottja, Portik Tamás pedig életfogytiglant. Vendégeink elmesélik, hogyan emlékeznek vissza a 98-as eseményekre, illetve, hogy mit szólnak az ítélethez.



Wesley Sneijder sokkal inkább Thibaut Courtois hibájának…



Még mindig sokan nem ismerik fel, ha bántalmazó kapcsolatban élnek

A friss kutatások szerint a megoldás egy újfajta lámpa lehet